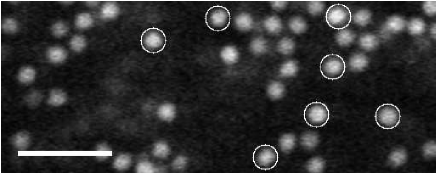
Refer to caption

Influence of Confinement on Dynamical Heterogeneities in Dense Colloidal Samples
Abstract
We study a dense colloidal suspension confined between two quasiparallel glass plates as a model system for a supercooled liquid in confined geometries. We directly observe the three-dimensional Brownian motion of the colloidal particles using laser scanning confocal microscopy. The particles form dense layers along the walls, but crystallization is avoided as we use a mixture of two particle sizes. A normally liquid-like sample, when confined, exhibits slower diffusive motion. Particle rearrangements are spatially heterogeneous, and the shapes of the rearranging regions are strongly influenced by the layering. These rearranging regions become more planar upon confinement. The wall-induced layers and changing character of the spatially heterogeneous dynamics appear strongly connected to the confinement induced glassiness.
pacs:
64.70.pv, 61.43.Fs, 82.70.DdI Introduction
As a glass-forming liquid is cooled, its viscosity increases smoothly but dramatically by many orders of magnitude. The macroscopic divergence in viscosity is related to the divergence in the microscopic structural relaxation time, or -relaxation time. A conceptual explanation is the Adams and Gibbs hypothesis, which states that the flow in a supercooled liquid involves the cooperative motion of molecules and that the structural arrest at the glass transition is due to a divergence of the size of these cooperatively rearranging regions (CRRs) Adam and Gibbs (1965).
Computer simulations and experiments have explored the sizes and shapes of regions of cooperatively moving molecules as a liquid’s glass transition is approached Kob et al. (1997a); Ediger (2000). A direct means of probing the dynamic length scales of glass-forming liquids is by confining them to smaller volumes, such as within thin films and nanopores. Confinement can either increase, decrease or even maintain a material’s glass transition temperature Alcoutlabi and McKenna (2005); Roth and Dutcher (2005). Both simulation and experiment suggest that the effect on depends on the nature of the interaction between the sample and its confining boundary Németh and Löwen (1999a); Scheidler et al. (2002); Ngai (2002); Sharp and Forrest (2003); Goel et al. (2008); Eral et al. (2009); Rice (2009). Attractive interactions may result in an increase in whereas repulsive interactions may result in a decrease Roth et al. (2007); Goel et al. (2008). Frustration of structural ordering, via a rough surface for example, can also play a key role, although this can either cause slower or faster dynamics Németh and Löwen (1999b); Scheidler et al. (2002); Eral et al. (2009). Whether or not the restriction of the length scales accessible to CRRs is responsible for the variation in remains to be seen due to the inability to directly observe molecular interactions within glass-forming liquids.
Instead of studying molecular glass-formers, we use dense colloidal suspensions of sterically-stabilized micrometer-sized spherical particles. Colloidal suspensions have often been used as experimental models of a hard sphere glass Pusey and van Megen (1986); van Blaaderen and Wiltzius (1995). We confine our samples within a planar volume formed by two quasi-parallel solid surfaces Nugent et al. (2007), similar to confined colloids studied by other groups Sarangapani and Zhu (2008); Eral et al. (2009); Sarangapani et al. (2011). We use high-speed confocal microscopy to rapidly visualize and acquire three-dimensional images of the particle positions Weeks et al. (2000); Dinsmore et al. (2001). Subsequent image analysis lets us track the individual particle trajectories, providing an accurate picture of the cooperatively rearranging groups of particles. Near the colloidal glass transition ( Pusey and van Megen (1986)), particles rearrange in groups characterized by a length scale of 3-6 particle diameters Weeks et al. (2000, 2007).

In this manuscript we further investigate our results from prior experiments that studied confined samples, as pictured in Fig. 1 Nugent et al. (2007). Here we focus specifically on the nature of cooperative rearrangements within the confined sample and how they relate to the system’s increased glassiness. In these experiments we found that confinement induces glassy behavior at concentrations in which the bulk behavior is still liquid-like. Here, we show that confining colloidal liquids within this planar volume results in cooperatively rearranging groups of particles that are similarly planar shaped. We find that the flattening shapes of the cooperatively rearranging groups are correlated with the overall slowing of the dynamics, suggesting a connection between confinement, wall-induced structure, and glassy behavior.
Understanding the effects of confinement on the glass transition may help us understand the glass transition in the bulk. Perhaps more importantly, understanding the properties of confined fluids also has direct relevance with lubrication Granick (1999), the flow of liquids through microfluidic devices Thompson et al. (1992); Goyon et al. (2008), and the kinetics of protein folding Zhou et al. (2008).
II Experimental Details
II.1 Colloidal samples and microscopy
We use spherical colloidal poly-methyl-methacrylate (PMMA) particles that are sterically stabilized to prevent interparticle attraction Pusey and van Megen (1986); Dinsmore et al. (2001). The particles are suspended in a mixture of solvents, cyclohexylbromide and cis- and trans-decalin, which matches both their density and index of refraction Dinsmore et al. (2001). While our sample is similar to other types of colloidal suspensions that act like hard spheres Pusey and van Megen (1986), the cyclohexylbromide in our solvent mixture induces a slight charge on the surfaces of the particles. Thus, the particles have a slightly soft repulsive interaction in addition to their hard sphere core. To prevent crystallization, which would be readily induced by the smooth walls in our thin planar geometry Grier and Murray (1994); Dullens and Kegel (2004), we use a binary mixture of particles with hydrodynamic radii of m and m. The number ratio is approximately , and the individual volume fractions are approximately , so the total overall volume fraction is . The uncertainty of arises from the difficulty in precisely determining the individual species’ particle size, the polydispersity of particle sizes ( for both species), and difficulties in determining the relative volume fractions of the two species Poon et al. (2012). A study of a similar colloidal mixture found the glass transition for bulk samples to be at Narumi et al. (2011).
We use laser scanning confocal microscopy to view the sample Dinsmore et al. (2001). We can acquire a three-dimensional image of the sample by scanning a m3 region (equal to pixels). We use Visitech’s “vt-Eye” confocal system which can scan this volume in 2.0 seconds. This is much faster than the time for particles to diffuse their own diameter, which is 100 seconds in our samples. We acquire sequences of three-dimensional (3D) confocal images every 2.0 seconds for up to 45 minutes. By scanning different locations, we observe the behavior at different chamber thicknesses ranging from 6 m to 19 m in addition to the sample’s bulk. Data representing the ‘bulk’ of our sample is acquired from a 20 m thick subvolume in the thicker region of the sample chamber that is over 15 m away from the chamber’s walls in order to avoid any boundary effects.
The small particles are dyed with Rhodamine dye Dinsmore et al. (2001) and the larger ones are left undyed. Thus the data in our results are for the smaller particles only. Each image is post-processed to find particle positions with an accuracy of 0.05 m in and (parallel to the walls) and 0.1 m in (perpendicular to the walls, and parallel to the optical axis of the microscope). Given that the particles do not move much between images, we can link the particle positions in time to get 3D trajectories of the particles’ motion throughout the sample volume Dinsmore et al. (2001); Crocker and Grier (1996).
II.2 Sample chambers
Our goal is to study our sample with a range of confinement thicknesses. Here we focus on “thin film like” confinement between two flat surfaces. We achieve this by constructing a wedge shaped sample chamber, as shown in Fig. 1. We build the chamber using a glass slide, a rectangular glass coverslip, and a narrow piece of a 60 m thick Mylar film, employing a method similar to the one used by Refs. Murray (1998); Fontecha et al. (2005). Using UV-curing epoxy (Norland 68) we attach the Mylar film near one end of one side of the glass slide so that it runs perpendicular to the slide’s length. Next, the glass coverslip is laid across the slide so that one end is raised up by the Mylar film. Meanwhile, the coverslip’s opposite end is clamped down, ensuring the thinnest gap size possible. We seal the sample chamber shut with epoxy, except for two small air holes; the sample is added via one while air escapes via the other. After adding the sample, the two openings are sealed with epoxy. The chamber’s shape is described in Fig. 1: a very long chamber with a broad range of thicknesses. Due to the Mylar film, the glass surfaces are not parallel but very slightly angled at relative to one another. Within our field of view, the change in our sample’s thickness due to our sample chamber’s slight taper is less than m, which is negligible for all but the thinnest regions. We do not see any influence of the taper in any of our results (discussed further below), suggesting it is reasonable to consider the two boundaries as locally quasi-parallel. We define as the direction along which varies.
When we fill our slides with sample, a small fraction of particles stick to the sample chamber’s walls. Typically less than of the walls’ area is coated with stuck particles Edmond et al. (2010). The stuck particles are easy to identify as their apparent motion, due to noise inherent to particle tracking, is much less than the other particles. An image showing the locations of some stuck particles is shown in Fig. 2. Other observations confirm that both large and small particles stick to the walls Edmond et al. (2010). We find that the particles stick to the surfaces of the glass slides only during the initial loading of the sample chamber with colloid. The stuck particles remain stuck indefinitely, through a van der Waals attraction to the glass, and are a permanent feature of the surface. The mobile particles do not stick to the sample’s glass boundaries over time – during the experiments they never are seen to stick, and over several months the amount of particles stuck to the glass does not appear to change. In fact, the mobile particles are repelled from the glass boundaries by a relatively weak Coulombic interaction; in other words, during the course of the experiment, the only particle-wall interaction is a weakly repulsive one. In a sample of dilute colloids, we observe that the concentration of particles is low at the wall and approaches the bulk value quickly, within m, suggesting that the Debye screening length is m at most and more likely m, in agreement with prior observations Royall et al. (2005). The stuck particles are expected to slightly slow adjacent particles Eral et al. (2011), which has been confirmed in our experimental data Edmond et al. (2010).
Particles do interact with the wall hydrodynamically. In the same dilute suspension, we measure particle mobility near the glass walls, with measured diffusivity shown in Fig. 3 as a function of the distance from the wall. The behavior (symbols) is in good agreement with Faxen’s Law (dashed line) Faxén (1922); Svoboda and Block (1994) which quantifies the hydrodynamic influence of a planar boundary. Of course, the hydrodynamic behavior is modified in confinement approaching quasi-two-dimensional situations, where the sample chamber thickness is comparable to the particle size Santana-Solano et al. (2005); Valley et al. (2007); Wonder et al. (2011). We do not consider experiments that are this thin; our observations all have . More significantly, for the larger volume fractions we consider in this work, the hydrodynamic interaction will be screened by the other particles, and so will not depend so strongly on the distance from the wall Michailidou et al. (2009); Wonder et al. (2011).

III Results
III.1 Wall-induced structure

We use the positions of the stuck particles to measure the local thickness of the sample chamber. To do this we find the number density as a function of the distance between the walls, shown in Fig. 4 for (a) the mobile particles and (b) the stuck particles. The maximum of each peak in (b) corresponds to the approximate position of the centers of the small particles stuck to the sample’s walls. These positions are marked by the vertical dashed lines in Fig. 4, whose separation indicate the effective local chamber thickness . Since only the small particles are visible to the microscope, the actual thickness is m. The mean particle radii are known only to within m, while our uncertainty in their positions is m. By averaging over tens of stuck particles we can determine to within m.
Figure 4(a) shows layering of particles near the sample walls, which has been seen in both computer simulations Németh and Löwen (1999a); Archer et al. (2007) and experiments Murray (1998); Dullens and Kegel (2004); Eral et al. (2009, 2011). Comparing Fig. 4(a) to (b) we see that the boundary layers of the mobile particles are offset from those of the stuck particles. The offset is due to Coulombic repulsion between the glass walls and PMMA particles, and is about 0.4 m in all cases. Using differential interference contrast (DIC) microscopy, we confirm that the large particles also form layers, albeit in positions shifted due to their size. Our results are qualitatively in agreement with simulations that studied layering of binary mixtures of particles near walls Desmond and Weeks (2009); Mittal et al. (2007), and are fairly similar to observations of layering in single-component colloidal samples Dullens and Kegel (2004); Eral et al. (2009, 2011).

Figure 5 displays the way layering changes with . The peaks of are tallest and thinnest next to the walls. Subsequent layers are shorter and wider, presumably as the correlations between particle positions become diluted through the presence of two particle sizes Desmond and Weeks (2009). Note that we do not see any “quantization” effects for particular values of Mittal et al. (2008). For example, some packing effects were seen in simulations at for integer values , but these effects are too subtle to be resolved given the relatively few values of for which we have experimental data Desmond and Weeks (2009).
III.2 Sample-averaged dynamics
Before we consider the specific influence of the particle layers on the particle motion, we will quantify the average motion of the sample. This is done by calculating the mean square displacement (MSD) as
where the average is taken over all particles and all initial times . Analogous formulas apply for and . Figure 6(a) shows that the motion parallel to the walls slows dramatically with confinement (decreasing , as indicated). For values less than m we observe a systematic slowdown.

The change of shape of the curves in Fig. 6(a) suggest that confinement induces caging dynamics. This is the inhibited motion of a particle due to its “cage” of neighboring particles Rabani et al. (1997); Kasper et al. (1998); Doliwa and Heuer (1998); Weeks and Weitz (2002); Reis et al. (2007). At the earliest times ( s, not shown), particle motion is diffusive as particles have not moved far enough to encounter the cage formed by the neighboring particles Tokuyama (2007). As the particle displacement becomes larger, its motion is impeded by its neighbors which form the cage, resulting in a greatly decreased slope of for s. For smaller values of , the decreasing height of in this range suggests that the cage size decreases in more confined samples. This is likely due to the concentration of particles into the layers (Fig. 5), which crowds them within the layers and reduces their cage sizes. Returning to Fig. 6(a), the upturn at larger for is the result of cage rearrangements Weeks et al. (2000); Kasper et al. (1998); Weeks and Weitz (2002); Scheidler et al. (2002). The neighbors rearrange and this lets the caged particle move to a new position. The motion of particles at longer lag times is diffusive due to the uncorrelated cage rearrangements Weeks and Weitz (2002); this is not quite seen in our data sets here as the time scales for this diffusive motion is longer than our observation times. The results shown are for one volume fraction; our prior work showed that for larger , the onset length scale for the confinement-induced slow-down increases Nugent et al. (2007).
To contrast the mobility in the parallel and perpendicular directions, in Fig. 6(c) we plot and separately for a selection of three thicknesses. Not surprisingly, the mobility is less in the direction (perpendicular to the wall). Furthermore, the upturn of the MSD at large is barely beginning for the data. The contrast between the and motion suggests that cage rearrangements may favor motions parallel to the walls.


The MSD curves show an overall slowing down due to confinement, but obscure the influence of the density layers on the motion. Figure 7(a) shows the number density for one data set. In panels (b) and (c) we plot the components of the MSD, for fixed values of , that are perpendicular and parallel to the walls. The dips in [Fig. 7(c)] coincide with the layers in panel (a) and imply that particles within layers are in a preferred structural configuration and are less likely to move elsewhere Nugent et al. (2007); Németh and Löwen (1999a); Archer et al. (2007); Mittal et al. (2008); Eral et al. (2009). Meanwhile, the parallel component of motion shows no variation with , even for long time scales. Our observations differ from one prior experiment by Eral et al. Eral et al. (2009). They found a decreased parallel mobility near the walls but did not measure perpendicular mobility. One difference is that they studied a single-component sample with a polydispersity of 8%, whereas we study a binary sample. Another difference is that their experiment had a spatial gradient in volume fraction due to non-density matched particles (they have a density difference between solvent and particles of kg/m3, much larger than our value kg/m3).
Intriguingly, our results shown in Figs. 5,7 look strikingly similar to recent experiments by Wonder, Lin, and Rice Wonder et al. (2011). They studied a monodisperse quasi-two-dimensional colloidal system, where particles were limited to one layer in , and further constricted in analogous to our confinement in . They found that their experimental short-time diffusion coefficients had a similar qualitative behavior to what is shown in Fig. 7(b,c) Wonder et al. (2011). They did not study long-time diffusion coefficients.
Our observed reduced particle mobility perpendicular to the walls is similar to the observations of Dullens and Kegel, who studied the first layer of colloidal particles at a smooth glass surface Dullens and Kegel (2004, 2005). In their work, quasi-two-dimensional (q-2D) layers of particles formed along the surface of a glass slide in a bulk polydisperse colloidal suspension, just as we observe. Their wall-based particles only intermittently exchanged with the bulk particles Dullens and Kegel (2005). In their q-2D wall layer, particles exhibited two-dimensional behavior that was fundamentally distinct from the dynamics of the particles further from the wall. However, a primary reason for this was that the particles were fairly monodisperse, and thus could form monodisperse 2D phases Dullens and Kegel (2004, 2005). In our experiments, the particle layers near the wall become more pronounced with decreasing , suggesting that these layers become more q-2D. However, our samples are binary and the two particle sizes remain well-mixed even at the walls (confirmed by DIC microscopy). While the q-2D nature of our layered particles may partially explain their slow motion, Fig. 7 shows that slowing is not restricted to these layers alone. Note that the hydrodynamic interaction of particles with nearby walls diminishes as the volume fraction is increased Michailidou et al. (2009).
One explanation for the slower dynamics might be that the volume fraction is larger in confinement. We first consider an observation from our experiment: the pair correlation function changes slightly upon confinement, as shown in Fig. 9. This function indicates the likelihood of finding a particle a distance away from a reference particle at , and so the first peak position indicates a typical spacing between nearest neighbor particles. For ideal hard spheres this first peak position is always at contact (). Our particles are slightly charged, so the first peak shifts to larger values. The peak is additionally rounded by our finite resolution and the particle polydispersity Narumi et al. (2011). Given the particle charges, an approximate expectation is that . The inset to Fig. 9 shows that confinement causes to shift to lower values, which would correspond in an increase of from 0.42 to 0.49. One explanation for this is that, given the layering of particles, the local volume fraction within a layer is higher than 0.42, and is reflecting this local volume fraction [which would be more heavily weighted in the average used to calculate ]. Another possible explanation is that the sample chamber is effectively thinner than we believe, due to the interactions between the particles and the walls. As noted above, the particle concentration is diminished within 0.4 m of the walls. At the thinnest regions we study, m; if the true value is m, this would correspond to an increase of from 0.42 to , consistent with the estimate from the data. However, an effective volume fraction increase from 0.42 to 0.49 seems unable to explain all of the dramatic slowing of the dynamics seen in Fig. 6(a). Consider the data at s: drops by a factor of going from the bulk to m. A study of an unconfined binary suspension similar to ours found a drop of for a change of from 0.42 to 0.49 Narumi et al. (2011). Thus we are left with a factor of ten in additional slowing which is not due to a possible volume fraction change. This agrees with the conclusions of Eral et al. Eral et al. (2009).

III.3 Defining cooperatively rearranging regions
The features of our curves resemble those of bulk supercooled colloidal liquids, where cage rearrangements play a significant role in the material’s underlying dynamics. The process of cage rearrangements leads to a liquid’s overall structural relaxation Ediger et al. (1996); Angell (2000). Adam and Gibbs were the first to hypothesize the existence of “cooperatively rearranging regions” (CRRs) as a supercooled liquid’s means of increasing its configurational entropy Adam and Gibbs (1965). Prior simulations Kob et al. (1997a); Appignanesi et al. (2006); Keyes et al. (2011) and experiments Marcus et al. (1999); Weeks et al. (2000); Kegel and van Blaaderen (2000) found cooperatively moving regions, defined as groups of neighboring molecules or particles that collectively rearrange their positions. The connection between these observations and the CRRs of Adam and Gibbs is perhaps problematic Dalle Ferrier et al. (2007) and there are other theories that also consider CRRs Ediger (2000); Hedges et al. (2009); Keyes et al. (2011). Independent of the theoretical status of CRRs, it is certainly intriguing that spatially heterogeneous dynamics have been seen in a wide range of glass-forming systems Ediger (2000). We wish to see how the character of spatially heterogeneous motions changes upon confinement.
The precise definition of a cooperatively rearranging region is open to interpretation. Our definition is described below, and is comprised of three key elements: (1) the time scale used to determine displacements, (2) the threshold for considering a displacement to be a “rearrangement,” and (3) the definition of which particles are adjacent, such that their motion is “cooperative.”

We first define the time scale of interest. Prior work found that a good choice is based on the shape of the probability distribution of displacements. Rearranging particles have displacements which are larger than normal, and thus lie in the tails of the distribution Kob et al. (1997b); Donati et al. (1998); Kegel and van Blaaderen (2000); Weeks et al. (2000); Marcus et al. (1999). The size of the distribution tails is quantified by the non-Gaussian parameter ,
from Ref. Rahman (1964). The maximum of defines the cage rearrangement time scale . We plot in Fig. 6(b): both the maximum value of and the time scale increase with decreasing , similar to prior observations on a monodisperse sample Sarangapani et al. (2011). For data from m, the levels of noise at low values of manifest as a false increase of , so we ignore this peak. For s there are secondary local maxima of that we consider to be a better determinant of [see the inset plot of Fig. 6(b)]. We plot versus in Fig. 10(a), which decays roughly exponentially with until m, at which it reaches the bulk value. Simply put, as decreases the displacement distributions become less Gaussian-like, and the time scale for which the distributions are most extreme grows.
To define the length scale which separates a “rearranging” displacement from a “caged” displacement, we use a mobility threshold . Both experiments Weeks et al. (2000); Keys et al. (2007) and simulations Donati et al. (1999) have used a displacement threshold to define mobility such that over time, some percentage of the particles have displacements Kob et al. (1997a); Donati et al. (1999), although at any given time the fraction may not be exactly this percentage. Thresholds of the top percentile Weeks et al. (2000); Donati et al. (1999), percentile Weeks and Weitz (2002), percentile Keys et al. (2007), and percentile Lynch et al. (2008) have all been used to define . From examining distributions of and for our data for each , we find that the slowest 90% of the displacements are well described by a Gaussian distribution, whereas the top 10% are more probable than a Gaussian distribution would predict. Thus, we define our mobility threshold as the top of the most mobile particles. Displacements in the -direction, however, vary significantly with , making their inclusion in the calculation of our threshold impractical. As is the case with prior studies Weeks et al. (2000); Kob et al. (1997a), our choice of is somewhat arbitrary and our results are robust to some variation of .
To complete our identification of CRRs we must identify which highly mobile particles are simultaneously nearest neighbors. Similar to other work, we define neighbors as those particles whose separation is less than a cutoff distance set by the first minimum of the pair correlation function Weeks and Weitz (2002). Our distributions of do not vary substantially with , as shown in Fig. 9. We use the average position of the first minimum (3.87 m) to define particles which are nearest neighbors.
One problem we face is the selective visibility of the colloidal particles. As discussed earlier, only the smaller particles of our binary suspension are fluorescently labeled meaning that the larger species of particles are not visible to our confocal microscope. Despite this limitation we can still draw some reasonable conclusions. For example, in a study of the aging of a binary colloidal suspension similar to the one studied here, Lynch et al. showed that the cooperative dynamics of one species were similar to that of the other Lynch et al. (2008). Mobile particles of one species were usually near mobile particles of the other species. Therefore, it is reasonable to draw some conclusions about cooperative motion from the small particles alone. One other related limitation is that small rearranging particles may not be nearest neighbors, but may be part of the same CRR, connected by unseen large particles. This is beyond our ability to determine, although it may simply limit the apparent sizes of CRRs without otherwise changing their character.
III.4 Shapes of Cooperatively Rearranging Regions
We first visualize these CRRs to develop a qualitative understanding of their nature. Figure 11 depicts clusters of the top percentile of the most mobile particles in a sample confined within a plate-spacing of m and m (panels (a,b) and (c,d) respectively). For clarity, bonds have been drawn between particles that are nearest neighbors, i.e. within a cluster. For both thicknesses, groups of mobile particles can be seen. The size of these mobile clusters in the unconfined sample is small, as expected for this low volume fraction () Weeks et al. (2000). Despite their small size, these mobile clusters are the primary means for particle rearrangments in the sample. The sample can be considered as composed of the slowest 90% particles which are caged at a given moment, and the rearranging fastest 10%. If the nature of the fastest 10% changes in confinement – for example, if those rearrangements occur less frequently – then the overall sample diffusivity will decrease.

Confinement induces slower dynamics, and in the bulk slower dynamics are associated with larger CRRs Kegel and van Blaaderen (2000); Weeks et al. (2000). Perhaps confinement induces a similar larger size of CRRs Sarangapani et al. (2011); but at first glance, comparing Fig. 11 panels (a) and (c) might suggest that the cluster sizes are smaller upon confinement. However, recall that the particles shown are the most mobile 10%; the thinner sample has fewer particles in the imaged volume, and thus 10% of this smaller number results in fewer mobile particles to show without necessarily implying that the CRRs are smaller. To quantify the size of CRRs we calculate the mean number of particles in a CRR as a function of , plotted in Fig. 10(b). Figure 10(b) shows that CRRs tend to involve roughly the same number of particles, regardless of thickness. The mean CRR size is between 3 and 4 particles, but this is only slightly larger than the minimum size of 3 particles. The small size may be because the bulk sample, with , is liquid-like and only has small CRRs Weeks et al. (2000). Alternatively, as noted above, we cannot see the large particles which are almost certainly part of CRRs Lynch et al. (2008). With the data of Fig. 10(b), we cannot say clearly if the CRRs are larger or smaller upon confinement. There is a very slight downward trend in with decreasing , but this could be due to poor statistics. It is possible that the influence of confinement on the size of CRRs would be clearer in a sample with a larger value of , although such samples are very difficult to load into our thin sample chambers (as has been noted by others Haw (2004); Isa et al. (2009)). Likely some of the difficulty in loading the samples is due to their increasing glassiness in confined spaces. Results from another confocal microscopy experiment on a monodisperse sample suggested that the length scale for CRRs grows upon confinement Sarangapani et al. (2011). The difference from our results may be due to our use of a binary sample.
An alternate way to quantify the size of a CRR is through its spatial extent. We define the spatial extent of the CRRs as , where ranges over all particles within a given cluster of mobile particles. Similar definitions apply for the and directions. We plot the mean CRR extent in the , and directions separately in Fig. 10(c). We find that the CRRs maintain a constant size in the direction parallel to the walls. However, the amount of distance that the CRRs extend in the direction perpendicular to the walls is significantly smaller than , and decreases as decreases. In the direction, then, clusters are smaller, perhaps trivially because CRRs have to fit into a thinner sample chamber. In the and direction, clusters maintain a constant size with confinement. Comparing this result with the data of Fig. 10(b) suggests that the CRRs are becoming more compact in with the same number of particles. This suggests that perhaps they are fractal in the bulk with a fractal dimension larger than 2 (as seen previously in Ref. Weeks et al. (2000)) and become more planar upon confinement (fractal dimension approaching 2).
The onset of flatter or more planar CRRs coincides with the sample’s overall slowing. In Fig. 10(d) we plot the MSD values from Fig. 6(a) for s against the corresponding range of . We observe that the MSD values of Fig. 10(d) begin to deviate from those of the bulk, indicated by the horizontal dashed line in (d), at approximately the same that the -extents of the CRRs first begin to flatten relative to the -extent from the bulk, the horizontal dashed line in (c). This is the strongest evidence linking the changing CRRs to the slowing dynamics. The overall concept is that confinement modifies the structure from that of the bulk, and this changed structure leads to slower dynamics Mittal et al. (2007).

We can more carefully quantify the shapes of the CRRs by considering the probability distributions of the extents in the three directions. These distributions are shown in Fig. 12 for a bulk sample (panel a) and a confined sample (panel b). In the unconfined sample the probabilities of the extent in the , , and directions are approximately the same, as should be expected; these CRRs are spatially isotropic. Differences in the are most likely due to minor particle position errors which are larger in , as discussed in Sec. II. In contrast with Fig. 12(a), Fig. 12(b) shows that the extents of CRRs in confinement have a very different probability distribution. The extent in is nearly zero for a majority of CRRs [red (dark gray) curve in Fig. 12(b)]; these are planar CRRs and are overwhelmingly more probable than in the unconfined case. A small subset of confined CRRs do extend into the -direction by one to two particle diameters. The clusters of rearranging particles along the walls in Fig. 11(c, d) seem to be the most planar in shape. Thus we are led to conclude that the CRRs in the confined cases are qualitatively different than those of the unconfined sample.
III.5 Details of Rearrangements
We next investigate the behavior of particles within CRRs. In Fig. 11 the particles are colored in correspondence with their amount of perpendicular motion, as shown in the key. In the confined situation mobile particles displace horizontally more frequently than otherwise, as suggested by the greater number of orange (medium gray) particles in Fig. 11(c, d), This makes sense: a rearrangement consisting of particles within a single layer does not require the particles to move vertically for the rearrangement to occur. Occasionally we do see particles which jump between layers or even swap between layers; one example is near the bottom right corner of Fig. 11(c).

To compare the amount of parallel versus perpendicular displacements, we calculate the directions of motion for all particles and then repeat the comparison for different confinement thicknesses. Using a spherical coordinate system we determine the polar angle of a given particle displacement. The polar angle spans a range from to , which correspond to motion toward or away from the nearest sample chamber wall, respectively. That is, we exploit the symmetry between the two walls. We first compute the polar angle relative to the axis, and then use for the data in the lower half of the sample chamber. Comparing the data separately for the top and bottom half, we find no difference in the results. For isotropic motion, the distribution of is proportional to , so we divide our measured histograms by to remove this dependence. The distributions are plotted in polar coordinates, shown in Fig. 13, for thicknesses of m and m. The dark curves are for all particles, and the light curves are for the top percentile of displacements, providing insight into the directions that tend to permit higher mobility. The top panels show the motion of the particles in the interior of the sample, and the bottom panels show the motion of the particles immediately adjacent to the walls.
In both the m and m samples, the particles in the outer layers along the walls tend to move parallel to them () rather than perpendicularly [Fig. 13(c, d)]. The effect is even more pronounced for the fastest particles, whose distribution suggests that fast particles move almost exclusively along the walls. This agrees with our observations from Fig. 11(b, d), where the particles layered along the walls are almost all orange (medium gray), indicating they are moving primarily horizontally. The distributions in Fig. 13(c, d) do show some data at , indicating that some particles move away from the walls, and less data at , indicating that some particles make slight motions toward the walls.
The situation changes markedly for the inner layers [Fig. 13(a, b)]. Considering only the full distribution of all particles we see that the displacements are more isotropic, although there is still a slight bias in the direction. The distribution of directions for the most mobile interior particles is similar. There are bumps in these distributions near and , which suggests that particles that move in have a slight increased probability to make large motions in , hopping between layers.
Overall, the particle dynamics in the thicker region are far more isotropic than the ones from the confined region [compare Fig. 13(a, c) with (b, d)]. In the m case, there are appreciable signs of anisotropic behavior only along the walls.
IV Conclusion
The smooth quasi-parallel walls confining our sample induce the formation of density layers within the colloidal sample’s volume. The most dense layers form along the sample chamber’s glass surfaces, as shown in Fig. 5 and also observed in other experimental work that used single-component colloidal samples Dullens and Kegel (2004); Eral et al. (2009). The structural inhomogeneities induced by the density layers result in corresponding inhomogeneities in the system’s dynamics, as described by the plots in Fig. 7. Particles move most easily within their layer, but this is still slower than they would move in unconfined samples. The layered particles cooperatively rearrange within the layer but rarely with adjacent layers; the cooperative rearrangements occur in more planar-shaped groups of particles. Given that even in unconfined samples, particles need to move cooperatively if they wish to have large displacements, the change in the character of the cooperatively rearranging regions seems to explain the slowing dynamics. In short, the thickness at which we begin to observe the slowing in the sample’s average dynamics corresponds with the confinement length scale at which cooperatively rearranging regions begin to become planar in shape [Figs. 10(c) and (d)]. Our prior work suggests that the observed increase in rearrangement time scales and the thickness at which these regions begin to flatten will both grow with higher volume fractions Nugent et al. (2007).
It is likely if the walls were roughened, the results might change. Simulations Németh and Löwen (1999a); Scheidler et al. (2002); Goel et al. (2008) and experiments Eral et al. (2009, 2011) showed that behavior is often glassier with rough walls. With rough walls, layering is greatly diminished or prevented entirely, or perhaps becomes more subtle. For example, particles might form a corrugated layer wrapping around the local wall texture. This could then lead to other shapes for the cooperatively rearranging regions; the main point being that structure that departs from the bulk results in slower dynamics Mittal et al. (2007).
V Acknowledgments
We thank M.H.G. Duits, H.B. Eral, and G.L. Hunter for helpful discussions. Funding for this work was provided by the National Science Foundation (DMR-0804174).
References
- Adam and Gibbs (1965) G. Adam and J. H. Gibbs, J. Chem. Phys. 43, 139 (1965).
- Kob et al. (1997a) W. Kob, C. Donati, S. J. Plimpton, P. H. Poole, and S. C. Glotzer, Phys. Rev. Lett. 79, 2827 (1997a).
- Ediger (2000) M. D. Ediger, Ann. Rev. Phys. Chem. 51, 99 (2000).
- Alcoutlabi and McKenna (2005) M. Alcoutlabi and G. B. McKenna, J. Phys.: Cond. Matt. 17, R461 (2005).
- Roth and Dutcher (2005) C. B. Roth and J. R. Dutcher, Journal of Electroanalytical Chemistry 584, 13 (2005).
- Németh and Löwen (1999a) Z. T. Németh and H. Löwen, Phys. Rev. E 59, 6824 (1999a).
- Scheidler et al. (2002) P. Scheidler, W. Kob, and K. Binder, Europhys. Lett. 59, 701 (2002).
- Ngai (2002) K. L. Ngai, Phil. Mag. B 82, 291 (2002).
- Sharp and Forrest (2003) J. S. Sharp and J. A. Forrest, Phys. Rev. Lett. 91, 235701 (2003).
- Goel et al. (2008) G. Goel, W. P. Krekelberg, J. R. Errington, and T. M. Truskett, Phys. Rev. Lett. 100, 106001 (2008).
- Eral et al. (2009) H. B. Eral, D. van den Ende, F. Mugele, and M. H. G. Duits, Phys. Rev. E 80, 061403 (2009).
- Rice (2009) S. A. Rice, Chem. Phys. Lett. 479, 1 (2009).
- Roth et al. (2007) C. B. Roth, K. L. McNerny, W. F. Jager, and J. M. Torkelson, Macromolecules 40, 2568 (2007).
- Németh and Löwen (1999b) Z. T. Németh and H. Löwen, Phys. Rev. E 59, 6824 (1999b).
- Pusey and van Megen (1986) P. N. Pusey and W. van Megen, Nature 320, 340 (1986).
- van Blaaderen and Wiltzius (1995) A. van Blaaderen and P. Wiltzius, Science 270, 1177 (1995).
- Nugent et al. (2007) C. R. Nugent, K. V. Edmond, H. N. Patel, and E. R. Weeks, Phys. Rev. Lett. 99, 025702 (2007).
- Sarangapani and Zhu (2008) P. S. Sarangapani and Y. Zhu, Phys. Rev. E 77, 010501 (2008).
- Sarangapani et al. (2011) P. S. Sarangapani, A. B. Schofield, and Y. Zhu, Phys. Rev. E 83, 030502 (2011).
- Weeks et al. (2000) E. R. Weeks, J. C. Crocker, A. C. Levitt, A. Schofield, and D. A. Weitz, Science 287, 627 (2000).
- Dinsmore et al. (2001) A. D. Dinsmore, E. R. Weeks, V. Prasad, A. C. Levitt, and D. A. Weitz, App. Optics 40, 4152 (2001).
- Weeks et al. (2007) E. R. Weeks, J. C. Crocker, and D. A. Weitz, J. Phys.: Cond. Matt. 19, 205131 (2007).
- Granick (1999) S. Granick, Physics Today 52, 26 (1999).
- Thompson et al. (1992) P. A. Thompson, G. S. Grest, and M. O. Robbins, Phys. Rev. Lett. 68, 3448 (1992).
- Goyon et al. (2008) J. Goyon, A. Colin, G. Ovarlez, A. Ajdari, and L. Bocquet, Nature 454, 84 (2008).
- Zhou et al. (2008) H. X. Zhou, G. Rivas, and A. P. Minton, Ann. Rev. Biophys. 37, 375 (2008).
- Grier and Murray (1994) D. G. Grier and C. A. Murray, J. Chem. Phys. 100, 9088 (1994).
- Dullens and Kegel (2004) R. P. A. Dullens and W. K. Kegel, Phys. Rev. Lett. 92, 195702 (2004).
- Poon et al. (2012) W. C. K. Poon, E. R. Weeks, and C. P. Royall, Soft Matter 8, 21 (2012).
- Narumi et al. (2011) T. Narumi, S. V. Franklin, K. W. Desmond, M. Tokuyama, and E. R. Weeks, Soft Matter 7, 1472 (2011).
- Crocker and Grier (1996) J. C. Crocker and D. G. Grier, J. Colloid Interf. Sci. 179, 298 (1996).
- Murray (1998) C. Murray, MRS Bulletin 23, 33 (1998).
- Fontecha et al. (2005) A. B. Fontecha, H. J. Schöpe, H. König, T. Palberg, R. Messina, and H. Löwen, J. Phys.: Cond. Matt. 17, S2779 (2005).
- Edmond et al. (2010) K. V. Edmond, C. R. Nugent, and E. R. Weeks, Euro. Phys. J. - Spec. Top. 189, 83 (2010).
- Royall et al. (2005) C. P. Royall, R. van Roij, and A. van Blaaderen, J. Phys.: Cond. Matt. 17, 2315 (2005).
- Eral et al. (2011) H. B. Eral, F. Mugele, and M. H. G. Duits, Langmuir 27, 12297 (2011).
- Faxén (1922) H. Faxén, Ann. Phys. 373, 89 (1922).
- Svoboda and Block (1994) K. Svoboda and S. M. Block, Ann. Rev. Biophys. Biomol. Struct. 23, 247 (1994).
- Santana-Solano et al. (2005) J. Santana-Solano, A. Ramírez-Saito, and J. Luis, Phys. Rev. Lett. 95, 198301 (2005).
- Valley et al. (2007) D. T. Valley, S. A. Rice, B. Cui, H. M. Ho, H. Diamant, and B. Lin, J. Chem. Phys. 126, 134908 (2007).
- Wonder et al. (2011) E. Wonder, B. Lin, and S. A. Rice, Phys. Rev. E 84, 041403 (2011).
- Michailidou et al. (2009) V. N. Michailidou, G. Petekidis, J. W. Swan, and J. F. Brady, Phys. Rev. Lett. 102, 068302 (2009).
- Archer et al. (2007) A. J. Archer, P. Hopkins, and M. Schmidt, Phys. Rev. E 75, 040501 (2007).
- Desmond and Weeks (2009) K. W. Desmond and E. R. Weeks, Phys. Rev. E 80, 051305 (2009).
- Mittal et al. (2007) J. Mittal, V. K. Shen, J. R. Errington, and T. M. Truskett, J. Chem. Phys. 127, 154513 (2007).
- Mittal et al. (2008) J. Mittal, T. M. Truskett, J. R. Errington, and G. Hummer, Phys. Rev. Lett. 100, 145901 (2008).
- Rabani et al. (1997) E. Rabani, D. J. Gezelter, and B. J. Berne, J. Chem. Phys. 107, 6867 (1997).
- Kasper et al. (1998) A. Kasper, E. Bartsch, and H. Sillescu, Langmuir 14, 5004 (1998).
- Doliwa and Heuer (1998) B. Doliwa and A. Heuer, Phys. Rev. Lett. 80, 4915 (1998).
- Weeks and Weitz (2002) E. R. Weeks and D. A. Weitz, Phys. Rev. Lett. 89, 095704 (2002).
- Reis et al. (2007) P. M. Reis, R. A. Ingale, and M. D. Shattuck, Phys. Rev. Lett. 98, 188301 (2007).
- Tokuyama (2007) M. Tokuyama, Physica A 378, 157 (2007).
- Dullens and Kegel (2005) R. P. A. Dullens and W. K. Kegel, Phys. Rev. E 71, 011405 (2005).
- Ediger et al. (1996) M. D. Ediger, C. A. Angell, and S. R. Nagel, J. Phys. Chem. 100, 13200 (1996).
- Angell (2000) C. A. Angell, J. Phys.: Cond. Matt. 12, 6463 (2000).
- Appignanesi et al. (2006) G. A. Appignanesi, J. A. R. Fris, R. A. Montani, and W. Kob, Phys. Rev. Lett. 96, 057801 (2006).
- Keyes et al. (2011) A. S. Keyes, L. O. Hedges, J. P. Garrahan, S. C. Glotzer, and D. Chandler, Phys. Rev. X 1, 021013 (2011).
- Marcus et al. (1999) A. H. Marcus, J. Schofield, and S. A. Rice, Phys. Rev. E 60, 5725 (1999).
- Kegel and van Blaaderen (2000) W. K. Kegel and A. van Blaaderen, Science 287, 290 (2000).
- Dalle Ferrier et al. (2007) C. Dalle Ferrier, C. Thibierge, C. A. Simionesco, L. Berthier, G. Biroli, J. P. Bouchaud, F. Ladieu, D. L’Hôte, and G. Tarjus, Phys. Rev. E 76, 041510 (2007).
- Hedges et al. (2009) L. O. Hedges, R. L. Jack, J. P. Garrahan, and D. Chandler, Science 323, 1309 (2009).
- Kob et al. (1997b) W. Kob, C. Donati, S. J. Plimpton, P. H. Poole, and S. C. Glotzer, Phys. Rev. Lett. 79, 2827 (1997b).
- Donati et al. (1998) C. Donati, J. F. Douglas, W. Kob, S. J. Plimpton, P. H. Poole, and S. C. Glotzer, Phys. Rev. Lett. 80, 2338 (1998).
- Rahman (1964) A. Rahman, Phys. Rev. 136, A405 (1964).
- Keys et al. (2007) A. S. Keys, A. R. Abate, S. C. Glotzer, and D. J. Durian, Nature Physics 3, 260 (2007).
- Donati et al. (1999) C. Donati, S. C. Glotzer, P. H. Poole, W. Kob, and S. J. Plimpton, Phys. Rev. E 60, 3107 (1999).
- Lynch et al. (2008) J. M. Lynch, G. C. Cianci, and E. R. Weeks, Phys. Rev. E 78, 031410 (2008).
- Haw (2004) M. D. Haw, Phys. Rev. Lett. 92, 185506 (2004).
- Isa et al. (2009) L. Isa, R. Besseling, A. N. Morozov, and W. C. K. Poon, Phys. Rev. Lett. 102, 058302 (2009).